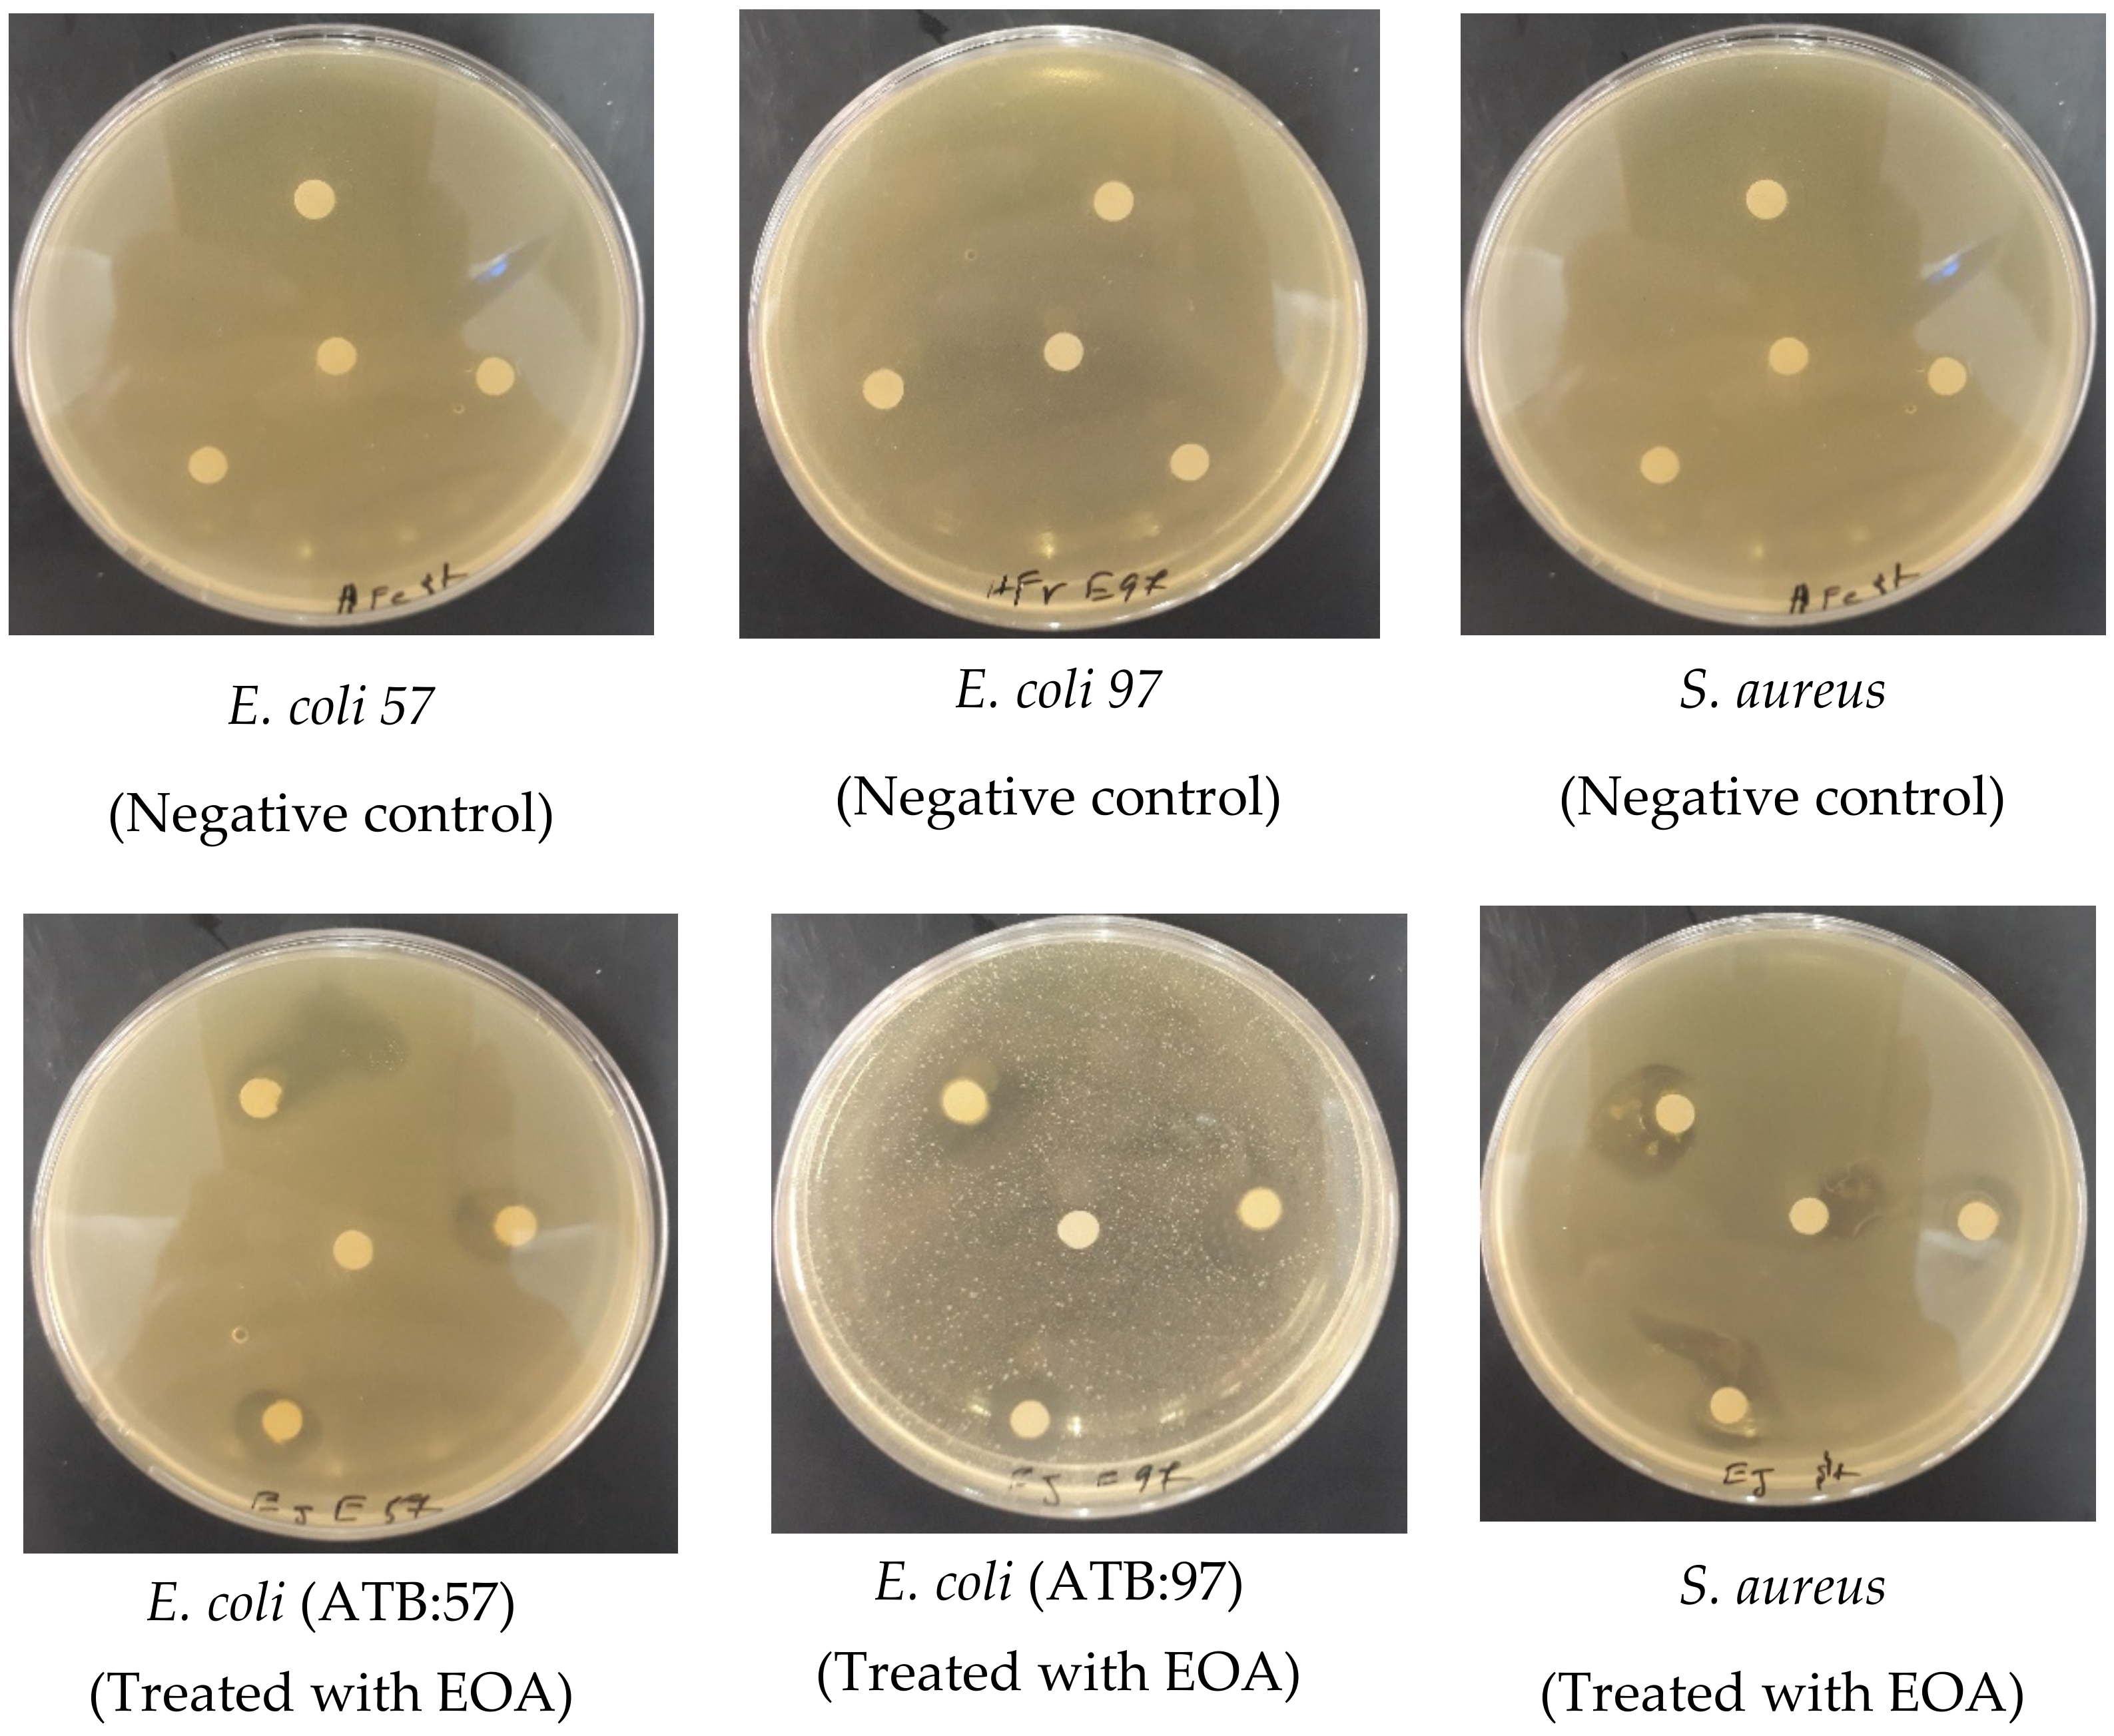
Molecules 27 01136 g005 550

Antioxidant and Antimicrobial Activities of Chemically-Characterized Essential Oil from Artemisia aragonensis Lam. against Drug-Resistant Microbes
Abstract
:1. Introduction
2. Materials and Methods
2.1. Plant Material Selection and Identification
2.2. Extraction of Essential Oil
2.3. Essential Oil Chemical Identification
2.4. Antioxidant Activity
2.4.1. Radical Scavenging Activity Test
2.4.2. Total Antioxidant Capacity Test (TAC)
2.4.3. Reducing Power Test (FRAP)
2.5. Antimicrobial Activity
2.5.1. Disk Diffusion Method
2.5.2. Determination of the Minimum Inhibitory Concentration (MIC)
2.6. Statistical Analysis
3. Results and Discussion
3.1. Essential Oil Yield
3.2. Chemical Composition Identification of the Essential Oil
3.3. Antioxidant Activities
3.3.1. Test DPPH

3.3.2. Total Antioxidant Capacity
3.3.3. Ferric Reducing Antioxidant Power Assay
3.4. Antibacterial and Antifungal Activity of EOA
3.4.1. Antibacterial Activity of Essential EOA
3.4.2. Antifungal Activity of the Essential Oil
4. Conclusions
Author Contributions
Funding
Institutional Review Board Statement
Informed Consent Statement
Data Availability Statement
Acknowledgments
Conflicts of Interest
Sample Availability
References
- Lis-Balchin, M.; Deans, S.G. Bioactivity of Selected Plant Essential Oils against Listeria Monocytogenes. J. Appl. Microbiol. 1997, 82, 759–762. [Google Scholar] [CrossRef]
- Kivrak, I.; Duru, M.E.; Öztürk, M.; Mercan, N.; Harmandar, M.; Topçu, G. Antioxidant, Anticholinesterase and Antimicrobial Constituents from the Essential Oil and Ethanol Extract of Salvia Potentillifolia. Food Chem. 2009, 116, 470–479. [Google Scholar] [CrossRef]
- Willcox, J.K.; Ash, S.L.; Catignani, G.L. Antioxidants and Prevention of Chronic Disease. Crit. Rev. Food Sci. Nutr. 2004, 44, 275–295. [Google Scholar] [CrossRef] [PubMed]
- Ames, B.N. Dietary Carcinogens and Anticarcinogens: Oxygen Radicals and Degenerative Diseases. Science 1983, 221, 1256–1264. [Google Scholar] [CrossRef] [PubMed] [Green Version]
- Roby, M.H.H.; Sarhan, M.A.; Selim, K.A.-H.; Khalel, K.I. Evaluation of Antioxidant Activity, Total Phenols and Phenolic Compounds in Thyme (Thymus vulgaris L.), Sage (Salvia officinalis L.), and Marjoram (Origanum majorana L.) Extracts. Ind. Crops Prod. 2013, 43, 827–831. [Google Scholar] [CrossRef]
- Vickers, N.J. Animal Communication: When I’m Calling You, Will You Answer Too? Curr. Biol. 2017, 27, R713–R715. [Google Scholar] [CrossRef] [PubMed]
- Buckner, M.M.; Ciusa, M.L.; Piddock, L.J. Strategies to Combat Antimicrobial Resistance: Anti-Plasmid and Plasmid Curing. FEMS Microbiol. Rev. 2018, 42, 781–804. [Google Scholar] [CrossRef] [PubMed] [Green Version]
- Venter, H.; Henningsen, M.L.; Begg, S.L. Antimicrobial Resistance in Healthcare, Agriculture and the Environment: The Biochemistry behind the Headlines. Essays Biochem. 2017, 61, 1–10. [Google Scholar] [CrossRef] [PubMed]
- O’Neill, J. Tackling Drug-Resistant Infections Globally: Final Report and Recommendations. Available online: https://apo.org.au/sites/default/files/resource-files/2016-05/apo-nid63983 (accessed on 11 December 2021).
- Amin, S.M.; Hassan, H.M.; El Gendy, A.E.-N.G.; El-Beih, A.A.; Mohamed, T.A.; Elshamy, A.I.; Bader, A.; Shams, K.A.; Mohammed, R.; Hegazy, M.-E.F. Comparative Chemical Study and Antimicrobial Activity of Essential Oils of Three Artemisia Species from Egypt and Saudi Arabia. Flavour Fragr. J. 2019, 34, 450–459. [Google Scholar] [CrossRef]
- Charchari, S.; Dahoun, A.; Bachi, F.; Benslimani, A. Antimicrobial Activity in Vitro of Essential Oils of Artemisia Herba-Alba Asso and Artemisia judaica L. from Algeria. Riv. Ital. EPPOS 1996, 18. [Google Scholar]
- Zeragui, B.; Hachem, K.; Halla, N.; Kahloula, K. Essential Oil from Artemisia Judaica L.(Ssp. Sahariensis) Flowers as a Natural Cosmetic Preservative: Chemical Composition, and Antioxidant and Antibacterial Activities. J. Essent. Oil Bear. Plants 2019, 22, 685–694. [Google Scholar] [CrossRef]
- Lopes-Lutz, D.; Alviano, D.S.; Alviano, C.S.; Kolodziejczyk, P.P. Screening of Chemical Composition, Antimicrobial and Antioxidant Activities of Artemisia Essential Oils. Phytochemistry 2008, 69, 1732–1738. [Google Scholar] [CrossRef] [PubMed]
- Ahmed, H.M. Ethnomedicinal, Phytochemical and Pharmacological Investigations of Perilla frutescens (L.) Britt. Molecules 2019, 24, 102. [Google Scholar] [CrossRef] [PubMed] [Green Version]
- El Barnossi, A.; Moussaid, F.; Housseini, A.I. Antifungal Activity of Bacillussp. Gn-A11-18isolated from Decomposing Solid Green Household Waste in Water and Soil against Candida Albicans and Aspergillus Niger. E3S Web Conf. 2020, 150, 02003. [Google Scholar] [CrossRef]
- Feuerstein, I.; Danin, A.; Segal, R. Constitution of the Essential Oil from an Artemisia Herba-Alba Population of Spain. Phytochemistry 1988, 27, 433–434. [Google Scholar] [CrossRef]
- Adams, R.P. Identification of Essential Oil Components by Gas Chromatography/Mass Spectrometry; Allured Publishing Corporation: Carol Stream, IL, USA, 2007; Volume 456. [Google Scholar]
- Chebbac, K.; Moussaoui, A.E.; Bourhia, M.; Salamatullah, A.M.; Alzahrani, A.; Guemmouh, R. Chemical Analysis and Antioxidant and Antimicrobial Activity of Essential Oils from Artemisia negrei L. against Drug-Resistant Microbes. Evid.-Based Complement. Altern. Med. 2021, 2021, 5902851. [Google Scholar] [CrossRef]
- Bourhia, M.; Laasri, F.E.; Aourik, H.; Boukhris, A.; Ullah, R.; Bari, A.; Ali, S.S.; El Mzibri, M.; Benbacer, L.; Gmouh, S. Antioxidant and Antiproliferative Activities of Bioactive Compounds Contained in Rosmarinus Officinalis Used in the Mediterranean Diet. Evid.-Based Complement. Altern. Med. 2019, 2019, 7623830. [Google Scholar] [CrossRef] [PubMed] [Green Version]
- Bourhia, M.; Elmoussaoui, A.; Kadiri, M.; Chedadi, M.; Agour, A.; Sfaira, M.; Bari, A. Promising Antioxidant and Anticorrosion Activities of Mild Steel in 1.0 M Hydrochloric Acid Solution by Withania frutescens L. Essential Oil. Front. Chem. 2021. [Google Scholar] [CrossRef]
- Balouiri, M.; Bouhdid, S.; Harki, E.; Sadiki, M.; Ouedrhiri, W.; Ibnsouda, S.K. Antifungal Activity of Bacillus Spp. Isolated from Calotropis Procera AIT. Rhizosphere against Candida Albicans. Asian J. Pham. Clin. Res. 2015, 8, 213–217. [Google Scholar]
- Ahmed, H.M.; Al-Zubaidy, A.M.A. Exploring Natural Essential Oil Components and Antibacterial Activity of Solvent Extracts from Twelve Perilla Frutescens L. Genotypes. Arab. J. Chem. 2020, 13, 7390–7402. [Google Scholar] [CrossRef]
- Elegbede, J.A.; Lateef, A.; Azeez, M.A.; Asafa, T.B.; Yekeen, T.A.; Oladipo, I.C.; Hakeem, A.S.; Beukes, L.S.; Gueguim-Kana, E.B. Silver-Gold Alloy Nanoparticles Biofabricated by Fungal Xylanases Exhibited Potent Biomedical and Catalytic Activities. Biotechnol. Prog. 2019, 35, e2829. [Google Scholar] [CrossRef]
- Balouiri, M.; Sadiki, M.; Ibnsouda, S.K. Methods for in Vitro Evaluating Antimicrobial Activity: A Review. J. Pharm. Anal. 2016, 6, 71–79. [Google Scholar] [CrossRef] [Green Version]
- Bencheqroun, H.K.; Ghanmi, M.; Satrani, B.; Aafi, A.; Chaouch, A. Activité Antimicrobienne Des Huiles Essentielles d’Artemisia Mesatlantica, Plante Endémique Du Maroc Antimicrobial Activity of the Essential Oil of an Endemic Plant in Morocco Artemisia Mesatlantica. Bull. Société R. Sci. Liège 2012, 81, 4–21. [Google Scholar]
- Bourhia, M.; Bouothmany, K.; Bakrim, H.; Hadrach, S.; Salamatullah, A.M.; Alzahrani, A.; Khalil Alyahya, H.; Albadr, N.A.; Gmouh, S.; Laglaoui, A. Chemical Profiling, Antioxidant, Antiproliferative, and Antibacterial Potentials of Chemically Characterized Extract of Citrullus colocynthis L. Seeds. Separations 2021, 8, 114. [Google Scholar] [CrossRef]
- Cui, S.; Zhang, S.; Ge, S.; Xiong, L.; Sun, Q. Green Preparation and Characterization of Size-Controlled Nanocrystalline Cellulose via Ultrasonic-Assisted Enzymatic Hydrolysis. Ind. Crops Prod. 2016, 83, 346–352. [Google Scholar] [CrossRef]
- El Abdali, Y.; Agour, A.; Allali, A.; Bourhia, M.; El Moussaoui, A.; Eloutassi, N.; Salamatullah, A.M.; Alzahrani, A.; Ouahmane, L.; Aboul-Soud, M.A.M.; et al. Lavandula dentata L.: Phytochemical Analysis, Antioxidant, Antifungal and Insecticidal Activities of Its Essential Oil. Plants 2022, 11, 311. [Google Scholar] [CrossRef]
- Ghanmi, M.; Satrani, B.; Aafi, A.; Isamili, M.R.; Houti, H.; Monfalouti, H.; Benchakroun, K.H.; Aberchane, M.; Harki, L.; Boukir, A. Effect of Harvest Period on Yield, Chemical Composition and Bioactiviy Sagebrush’s (Artemisia Herba-Alba) Essential Oils in Guercif (Eastern Region of Morocco). Phytotherapie 2010, 8, 295. [Google Scholar] [CrossRef]
- Paolini, J.; Ouariachi, E.; Bouyanzer, A.; Hammouti, B.; Desjobert, J.-M.; Costa, J.; Muselli, A. Chemical Variability of Artemisia Herba-Alba Asso Essential Oils from East Morocco. Chem. Pap. 2010, 64. [Google Scholar] [CrossRef]
- Aimad, A.; Sanae, R.; Anas, F.; Abdelfattah, E.M.; Bourhia, M.; Mohammad Salamatullah, A.; Alzahrani, A.; Alyahya, H.K.; Albadr, N.A.; Abdelkrim, A. Chemical Characterization and Antioxidant, Antimicrobial, and Insecticidal Properties of Essential Oil from Mentha pulegium L. Evid.-Based Complement. Altern. Med. 2021, 2021, 1108133. [Google Scholar] [CrossRef] [PubMed]
- Abdelfattah, E.M.; Aimad, A.; Bourhia, M.; Chebbac, K.; Salamatullah, A.M.; Soufan, W.; Nafidi, H.-A.; Aboul-Soud, M.A.M.; Ouahmane, L.; Bari, A. Insecticidal and Antifungal Activities of Chemically-Characterized Essential Oils from the Leaves of Withania frutescens L. Life 2022, 12, 88. [Google Scholar] [CrossRef]
- Bakkali, F.; Averbeck, S.; Averbeck, D.; Idaomar, M. Biological Effects of Essential Oils—A Review. Food Chem. Toxicol. 2008, 46, 446–475. [Google Scholar] [CrossRef]
- Chun, S.-S.; Vattem, D.A.; Lin, Y.-T.; Shetty, K. Phenolic Antioxidants from Clonal Oregano (Origanum Vulgare) with Antimicrobial Activity against Helicobacter Pylori. Process Biochem. 2005, 40, 809–816. [Google Scholar] [CrossRef]
- Svoboda, K.P.; Hampson, J.B. Bioactivity of Essential Oils of Selected Temperate Aromatic Plants: Antibacterial, Antioxidant, Antiinflammatory and Other Related Pharmacological Activities. Plant Biol. Dep. SAC Auchincruive 1999, 16, 1–7. [Google Scholar]
- Pandey, A.K.; Singh, P.; Tripathi, N.N. Chemistry and Bioactivities of Essential Oils of Some Ocimum Species: An Overview. Asian Pac. J. Trop. Biomed. 2014, 4, 682–694. [Google Scholar] [CrossRef] [Green Version]
- Graßmann, J. Terpenoids as Plant Antioxidants. Vitam. Horm. 2005, 72, 505–535. [Google Scholar] [PubMed]
- Zheng, W.; Wang, S.Y. Antioxidant Activity and Phenolic Compounds in Selected Herbs. J. Agric. Food Chem. 2001, 49, 5165–5170. [Google Scholar] [CrossRef] [PubMed]
- De Pinedo, A.T.; Peñalver, P.; Morales, J.C. Synthesis and Evaluation of New Phenolic-Based Antioxidants: Structure–Activity Relationship. Food Chem. 2007, 103, 55–61. [Google Scholar] [CrossRef]
- Popovici, C.; Saykova, I.; Tylkowski, B. Evaluation de l’activité Antioxydant Des Composés Phénoliques Par La Réactivité Avec Le Radical Libre DPPH. Rev. Génie Ind. 2009, 4, 25–39. [Google Scholar]
- Durazzo, A. Study Approach of Antioxidant Properties in Foods: Update and Considerations. Foods 2017, 6, 17. [Google Scholar] [CrossRef] [PubMed] [Green Version]
- Bouhdid, S.; Skali, S.N.; Idaomar, M.; Zhiri, A.; Baudoux, D.; Amensour, M.; Abrini, J. Antibacterial and Antioxidant Activities of Origanum Compactum Essential Oil. Afr. J. Biotechnol. 2008, 7, 1563–1570. [Google Scholar]
- Chalchat, J.-C.; Gorunovic, M.S.; Maksimovic, Z.A.; Petrovic, S.D. Essential Oil of Wild Growing Mentha pulegium L. from Yugoslavia. J. Essent. Oil Res. 2000, 12, 598–600. [Google Scholar] [CrossRef]
- Yadegarinia, D.; Gachkar, L.; Rezaei, M.B.; Taghizadeh, M.; Astaneh, S.A.; Rasooli, I. Biochemical Activities of Iranian Mentha piperita L. and Myrtus communis L. Essential Oils. Phytochemistry 2006, 67, 1249–1255. [Google Scholar] [CrossRef] [PubMed]
- Fayed, S.A. Antioxidant and Anticancer Activities of Citrus reticulate (Petitgrain Mandarin) and Pelargonium graveolens (Geranium) Essential Oils. Res. J. Agric. Biol. Sci. 2009, 5, 740–747. [Google Scholar]
- Mukazayire, M.-J.; Tomani, J.C.; Stévigny, C.; Chalchat, J.C.; Conforti, F.; Menichini, F.; Duez, P. Essential Oils of Four Rwandese Hepatoprotective Herbs: Gas Chromatography–Mass Spectrometry Analysis and Antioxidant Activities. Food Chem. 2011, 129, 753–760. [Google Scholar] [CrossRef] [PubMed]
- Carvalho, M.F.N.; Leite, S.; Costa, J.P.; Galvão, A.M.; Leitão, J.H. Ag (I) Camphor Complexes: Antimicrobial Activity by Design. J. Inorg. Biochem. 2019, 199, 110791. [Google Scholar] [CrossRef] [PubMed]
- Amrati, F.E.-Z.; Bourhia, M.; Saghrouchni, H.; Slighoua, M.; Grafov, A.; Ullah, R.; Ezzeldin, E.; Mostafa, G.A.; Bari, A.; Ibenmoussa, S. Caralluma europaea (Guss.) NE Br.: Anti-Inflammatory, Antifungal, and Antibacterial Activities against Nosocomial Antibiotic-Resistant Microbes of Chemically Characterized Fractions. Molecules 2021, 26, 636. [Google Scholar] [CrossRef] [PubMed]
- Burits, M.; Asres, K.; Bucar, F. The Antioxidant Activity of the Essential Oils of Artemisia afra, Artemisia abyssinica and Juniperus procera. Phytother. Res. 2001, 15, 103–108. [Google Scholar] [CrossRef]
- EL Moussaoui, A.; Bourhia, M.; Jawhari, F.Z.; Salamatullah, A.M.; Ullah, R.; Bari, A.; Majid Mahmood, H.; Sohaib, M.; Serhii, B.; Rozhenko, A. Chemical Profiling, Antioxidant, and Antimicrobial Activity against Drug-Resistant Microbes of Essential Oil from Withania frutescens L. Appl. Sci. 2021, 11, 5168. [Google Scholar] [CrossRef]
- Zouari, S.; Zouari, N.; Fakhfakh, N.; Bougatef, A.; Ayadi, M.A.; Neffati, M. Chemical Composition and Biological Activities of a New Essential Oil Chemotype of Tunisian Artemisia Herba Alba Asso. J. Med. Plants Res. 2010, 4, 871–880. [Google Scholar]
- Oussalah, M.; Caillet, S.; Saucier, L.; Lacroix, M. Inhibitory Effects of Selected Plant Essential Oils on the Growth of Four Pathogenic Bacteria: E. coli O157: H7, Salmonella typhimurium, Staphylococcus aureus and Listeria monocytogenes. Food Control 2007, 18, 414–420. [Google Scholar] [CrossRef]
- Dorman, H.-D.; Deans, S.G. Antimicrobial Agents from Plants: Antibacterial Activity of Plant Volatile Oils. J. Appl. Microbiol. 2000, 88, 308–316. [Google Scholar] [CrossRef] [PubMed]
- Faleiro, M.L.; Miguel, M.G.; Ladeiro, F.; Venancio, F.; Tavares, R.; Brito, J.C.; Figueiredo, A.C.; Barroso, J.G.; Pedro, L.G. Antimicrobial Activity of Essential Oils Isolated from Portuguese Endemic Species of Thymus. Lett. Appl. Microbiol. 2003, 36, 35–40. [Google Scholar] [CrossRef] [PubMed] [Green Version]
- Gafter-Gvili, A.; Vidal, L.; Goldberg, E.; Leibovici, L.; Paul, M. Treatment of Invasive Candidal Infections: Systematic Review and Meta-Analysis. Mayo Clin. Proc. 2008, 83, 1011–1021. [Google Scholar] [CrossRef] [PubMed]
- Jawhari, F.Z.; Moussaoui, A.E.; Bourhia, M.; Imtara, H.; Saghrouchni, H.; Ammor, K.; Ouassou, H.; Elamine, Y.; Ullah, R.; Ezzeldin, E. Anacyclus pyrethrum Var. pyrethrum (L.) and Anacyclus pyrethrum Var. depressus (Ball) Maire: Correlation between Total Phenolic and Flavonoid Contents with Antioxidant and Antimicrobial Activities of Chemically Characterized Extracts. Plants 2021, 10, 149. [Google Scholar] [CrossRef] [PubMed]
- Atkins, K.E.; Travis, J.M.J. Local Adaptation and the Evolution of Species’ Ranges under Climate Change. J. Theor. Biol. 2010, 266, 449–457. [Google Scholar] [CrossRef] [PubMed] [Green Version]
- Srivastava, J.P.; Lambert, J.; Vietmeyer, N. Medicinal Plants: An Expanding Role in Development; The World Bank: Washington, DC, USA, 1996. [Google Scholar]
- Yu, Z.; Tang, J.; Khare, T.; Kumar, V. The Alarming Antimicrobial Resistance in ESKAPEE Pathogens: Can Essential Oils Come to the Rescue? Fitoterapia 2020, 140, 104433. [Google Scholar] [CrossRef]
- Cosentino, S.; Tuberoso, C.I.G.; Pisano, B.; Satta, M.L.; Mascia, V.; Arzedi, E.; Palmas, F. In-Vitro Antimicrobial Activity and Chemical Composition of Sardinian Thymus Essential Oils. Lett. Appl. Microbiol. 1999, 29, 130–135. [Google Scholar] [CrossRef]
- Butler, M.S.; Blaskovich, M.A.; Cooper, M.A. Antibiotics in the Clinical Pipeline at the End of 2015. J. Antibiot. 2017, 70, 3–24. [Google Scholar] [CrossRef]
- Ellepola, A.N.B.; Samaranayake, L.P. Oral Candidal Infections and Antimycotics. Crit. Rev. Oral Biol. Med. 2000, 11, 172–198. [Google Scholar] [CrossRef] [PubMed] [Green Version]
- Swamy, M.K.; Akhtar, M.S.; Sinniah, U.R. Antimicrobial Properties of Plant Essential Oils against Human Pathogens and Their Mode of Action: An Updated Review. Evid.-Based Complement. Altern. Med. 2016, 2016, 3012462. [Google Scholar] [CrossRef] [PubMed]
- Turina, A.d.V.; Nolan, M.V.; Zygadlo, J.A.; Perillo, M.A. Natural Terpenes: Self-Assembly and Membrane Partitioning. Biophys. Chem. 2006, 122, 101–113. [Google Scholar] [CrossRef] [PubMed]
- Pina-Vaz, C.; Gonçalves Rodrigues, A.; Sansonetty, F.; Martinez-De-Oliveira, J.; Fonseca, A.F.; Mårdh, P.-A. Antifungal Activity of Local Anesthetics against Candida Species. Infect. Dis. Obstet. Gynecol. 2000, 8, 124–137. [Google Scholar] [CrossRef] [PubMed] [Green Version]
- Pina-Vaz, C.; Sansonetty, F.; Rodrigues, A.G.; Martinez-De-Oliveira, J.; Fonseca, A.F.; Mårdh, P.-A. Antifungal Activity of Ibuprofen Alone and in Combination with Fluconazole against Candida Species. J. Med. Microbiol. 2000, 49, 831–840. [Google Scholar] [CrossRef] [PubMed] [Green Version]

| RI | ||||||
|---|---|---|---|---|---|---|
| Area (%) | Lit | Obs | Chemical Classes | Compound Name | R.T (min) | P |
| 1.53 | 933 | 933 | MO.H | α-Pinene | 7.84 | 1 |
| 3.1 | 949 | 948 | MO.H | Camphene | 8.23 | 2 |
| 1.43 | 980 | 982 | MO.H | β-Pinene | 9.17 | 3 |
| 2.75 | 999 | 998 | MO.O | Yamogi alcohol | 10.15 | 4 |
| 0.69 | 1026 | 1024 | MO.H | o-Cymene | 10.78 | 5 |
| 10.88 | 1032 | 1030 | MO.O | 1,8-Cineole | 11.03 | 6 |
| 0.48 | 1017 | 1019 | MO.H | α-Terpinene | 12.15 | 7 |
| 10.2 | 1083 | 1089 | MO.O | Artemisia alcohol | 13.11 | 8 |
| 0.51 | 1102 | 1107 | MO.O | Thujone | 13.39 | 9 |
| 24.97 | 1146 | 1151 | MO.O | Camphor | 14.57 | 10 |
| 0.52 | 1139 | 1145 | MO.O | Trans-pinocarveol | 14.65 | 11 |
| 0.44 | 1164 | 1163 | MO.O | Pinocarvone | 15.16 | 12 |
| 13.2 | 1169 | 1171 | MO.O | Borneol | 15.66 | 13 |
| 1.39 | 1082 | 1084 | MO.O | Terpinen-4-ol | 16.09 | 14 |
| 1 | 1173 | 1178 | O | Artemisia acetate | 16.24 | 15 |
| 0.69 | 1133 | 1137 | MO.O | α–Terpineol | 16.51 | 16 |
| 2.73 | 1198 | 1195 | MO.O | Myrtenol | 16.73 | 17 |
| 0.42 | 1216 | 1220 | MO.O | Trans-Carveol | 17.46 | 18 |
| 1.44 | 1237 | 1239 | MO.O | Pulegone | 17.87 | 19 |
| 2.33 | 1288 | 1286 | O | Bornyl acetate | 19.8 | 20 |
| 0.83 | 1326 | 1327 | O | Myrtenyl acetate | 21.05 | 21 |
| 0.75 | 1376 | 1372 | SQ.H | α-Copaene | 23.11 | 22 |
| 0.71 | 1485 | 1480 | SQ.H | Germacrene D | 26.12 | 23 |
| 1.26 | 1578 | 1579 | SQ.O | Spathulenol | 28.66 | 24 |
| 1.26 | 1586 | 1583 | SQ.O | Caryophyllene oxide | 28.77 | 25 |
| 0.5 | 1624 | 1625 | SQ.O | Isospathulenol | 30.12 | 26 |
| 2.2 | 1632 | 1633 | SQ.O | γ-Eudesmo | 30.26 | 27 |
| 0.51 | 1640 | 1642 | SQ.O | Cadinol | 30.5 | 28 |
| 1.3 | 1650 | 1652 | SQ.O | β-Eudesmo | 30.64 | 29 |
| 0.45 | 1658 | 1657 | SQ.O | Bisabolol oxyde B | 30.93 | 30 |
| 5.63 | 1685 | 1688 | SQ.O | Bisabolone oxide A | 31.45 | 31 |
| 0.56 | 1749 | 1751 | SQ.O | α-Bisabolol oxide A | 33.14 | 32 |
| 1.33 | 2800 | 2804 | O | Octacosane | 40.32 | 33 |
| 1.63 | 2500 | 2503 | ST.H | Pentacosane | 42.99 | 34 |
| Chemical classes | ||||||
| 7.23 | Monoterpene hydrocarbons (MO.H) | |||||
| 70.14 | Oxygenated monoterpenes (MO.O) | |||||
| 1.46 | Sesquiterpene hydrocarbons (SQ.H) | |||||
| 13.67 | Oxygenated sesquiterpenes (SQ.O) | |||||
| 1.63 | Sesterpene (ST.H) | |||||
| 5.49 | Other compounds (O) | |||||
| 99.62 | Total identification | |||||
| Compound | Gram-Negative Bacteria | Gram-Positive Bacteria | ||
|---|---|---|---|---|
| E. coli (ATB:57) | E. coli (ATB:97) | S. aureus | B. subtilis | |
| Essential oil | 13.00 ± 0.00 a | 13.67 ± 1.15 a | 14.67 ± 0.58 a | 13.33 ± 0.58 a |
| Streptomycin | _ | _ | 9.11 ± 0.43 | _ |
| Ampicillin | _ | _ | _ | _ |
| Compound | Gram-Negative Bacteria | Gram-Positive Bacteria | ||
|---|---|---|---|---|
| E. coli (ATB:57) | E. coli (ATB:97) | S. aureus | B. subtilis | |
| EOA | 5.375 ± 0.00 a | 5.971 ± 1.033 a | 6.568 ± 1.033 a | 7.164 ± 0.0 a |
| Streptomycin | 0.25 ± 0.00 a | 0.5 ± 0.00 b | 0.062 ± 0.00 c | _ |
| Ampicillin | _ | _ | _ | _ |
| Inhibition Diameter (mm) | Minimum Inhibitory Concentration (µg/mL) | |||
|---|---|---|---|---|
| Fungal Strains | EOA | Fluconazole | EOA | Fluconazole |
| A. niger | 68.51 ± 1.06 a | 36.12 ± 3.70 b | 21.50 ± 0.43 c | 2.01 ± 0.01 d |
| A. flavus | 71.72 ± 0.52 a | 29.41 ± 5.07 b | 5.31 ± 0.10 c | 1.21 ± 0.01 d |
| F. oxysporum | 46.50 ± 1.01 a | 39.52 ± 2.16 a | 21.50 ± 0.46 a | 1.82 ± 0.01 d |
| C. albicans | 40.00 ± 1.0 a | 33.08 ± 4.17 a | 5.30 ± 0.036 c | 3.12 ± 0.20 d |
Publisher’s Note: MDPI stays neutral with regard to jurisdictional claims in published maps and institutional affiliations. |
© 2022 by the authors. Licensee MDPI, Basel, Switzerland. This article is an open access article distributed under the terms and conditions of the Creative Commons Attribution (CC BY) license (https://creativecommons.org/licenses/by/4.0/).
Share and Cite
Chebbac, K.; Ghneim, H.K.; El Moussaoui, A.; Bourhia, M.; El Barnossi, A.; Benziane Ouaritini, Z.; Salamatullah, A.M.; Alzahrani, A.; Aboul-Soud, M.A.M.; Giesy, J.P.; et al. Antioxidant and Antimicrobial Activities of Chemically-Characterized Essential Oil from Artemisia aragonensis Lam. against Drug-Resistant Microbes. Molecules 2022, 27, 1136. https://doi.org/10.3390/molecules27031136
Chebbac K, Ghneim HK, El Moussaoui A, Bourhia M, El Barnossi A, Benziane Ouaritini Z, Salamatullah AM, Alzahrani A, Aboul-Soud MAM, Giesy JP, et al. Antioxidant and Antimicrobial Activities of Chemically-Characterized Essential Oil from Artemisia aragonensis Lam. against Drug-Resistant Microbes. Molecules. 2022; 27(3):1136. https://doi.org/10.3390/molecules27031136
Chicago/Turabian StyleChebbac, Khalid, Hazem K. Ghneim, Abdelfattah El Moussaoui, Mohammed Bourhia, Azeddin El Barnossi, Zineb Benziane Ouaritini, Ahmad Mohammad Salamatullah, Abdulhakeem Alzahrani, Mourad A. M. Aboul-Soud, John P. Giesy, and et al. 2022. "Antioxidant and Antimicrobial Activities of Chemically-Characterized Essential Oil from Artemisia aragonensis Lam. against Drug-Resistant Microbes" Molecules 27, no. 3: 1136. https://doi.org/10.3390/molecules27031136
APA StyleChebbac, K., Ghneim, H. K., El Moussaoui, A., Bourhia, M., El Barnossi, A., Benziane Ouaritini, Z., Salamatullah, A. M., Alzahrani, A., Aboul-Soud, M. A. M., Giesy, J. P., & Guemmouh, R. (2022). Antioxidant and Antimicrobial Activities of Chemically-Characterized Essential Oil from Artemisia aragonensis Lam. against Drug-Resistant Microbes. Molecules, 27(3), 1136. https://doi.org/10.3390/molecules27031136

